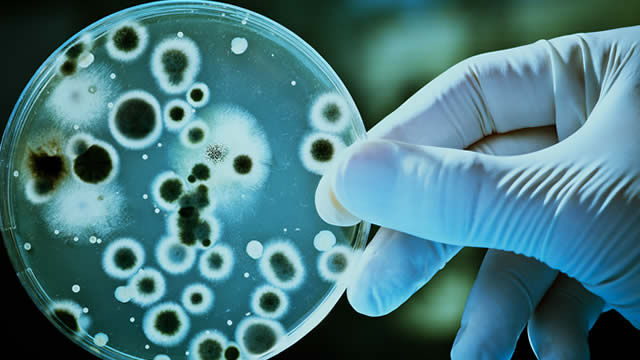
Sarepta Stock Plummets 23%. Here's Why.

Sarepta Therapeutics Inc. (SRPT)

Sarepta shares sink on third gene therapy-linked death
Sarepta Therapeutics Inc (NASDAQ:SRPT) shares pulled back after Thursday's gains on the announcement of a third patient death linked to the company's experimental gene therapies. The patient, who was participating in a Phase 1 trial for Sarepta's approved AAVrh74-based gene therapy targeting limb-girdle muscular dystrophy, died from acute liver failure.
Sarepta Stock Plummets 23%. Here's Why.
The drop comes the day after the drugmaker said it would add a so-called black-box warning to its gene therapy Elevidys after two teenage boys receiving the treatment died earlier this year.

SRPT Stock Soars on Unveiling New Restructuring Plan, Pipeline Pivots
Sarepta's shares jump after unveiling a major restructuring plan to cut costs. The company shifts focus to siRNA and reprioritizes its pipeline.

Sarepta shares soar on restructuring, R&D refocus
Sarepta Therapeutics Inc (NASDAQ:SRPT) shares jumped on a sweeping restructuring plan that includes cutting about 500 jobs, or 36% of its workforce, in a move aimed at reducing annual operating expenses by $400 million by 2026. The biotech company said it will sharpen its focus on high-impact drug development programs, particularly its small interfering RNA (siRNA) platform targeting neurodegenerative and pulmonary diseases such as facioscapulohumeral muscular dystrophy (FSHD), myotonic dystrophy type 1, and Huntington's disease.

Biotech Stock Soars on Restructuring Plan, Layoffs
Biopharma stock Sarepta Therapeutics Inc (NASDAQ:SRPT) is soaring today, up 20.6% at $22.17 at last glance.

Sarepta Therapeutics: What's Happening With SRPT Stock?
Sarepta Therapeutics stock (NASDAQ: SRPT) experienced a significant turnaround on Wednesday, with shares rising 33% in after-hours trading following the announcement of an extensive restructuring plan, which involves laying off 500 employees — nearly 40% of its workforce of over 1,300. The company also plans to halt several gene therapy programs, including the majority of its limb-girdle muscular dystrophy initiatives.

Sarepta Stock Soars 30%. Why Layoffs and a ‘Black-Box' Warning Are Good News.
The pharma company said it would lay off a third of its workforce and add a black-box warning to its controversial gene therapy Elevidys.

Sarepta: Finally, A Little Relief For Bulls; I Expect More
Sarepta's turnaround is just beginning, with decisive management actions like layoffs boosting confidence and saving $100 million annually. The market had priced in the worst for Elevidys, but the FDA's black box warning was a positive surprise, opening potential future catalysts. Sarepta is not a one-trick pony; upcoming clinical results for SRP-9003 and other pipeline assets add upside optionality.

Sarepta Drops 42% on Fatalities; Markets Eye Solid Biosciences
In another tragic incident, Sarepta Therapeutics NASDAQ: SRPT saw a second death in connection with its Duchenne muscular dystrophy (DMD) treatment ELEVIDYS. The patient passed away due to acute liver failure (ALF) after doctors treated them with ELEVIDYS.

SRPT Stock: What's Happening With Sarepta Therapeutics?
Sarepta Therapeutics (NASDAQ: SRPT) suffered a devastating blow on Monday, June 16 when its stock plummeted 42% following news of a second patient death linked to its Duchenne muscular dystrophy gene therapy, Elevidys. The biotechnology company and its global partner Roche immediately suspended commercial and clinical use of the treatment in non-ambulatory patients pending a comprehensive safety review.

SRPT Down Near 9-Year Low, CSCO Upgrade, ROKU Using AMZN Ads
Sarepta Therapeutics (SRPT) sold off more than 40% after suspending its Elevidys Duchenne muscular dystrophy drug, which was linked to two fatal liver failure cases. Diane King Hall break takes a closer look into the report.

SRPT Plummets on Second Patient Death After DMD Gene Therapy Infusion
Sarepta's shares sink as second Elevidys-linked death triggers safety concerns, dosing halts and trial pauses.







